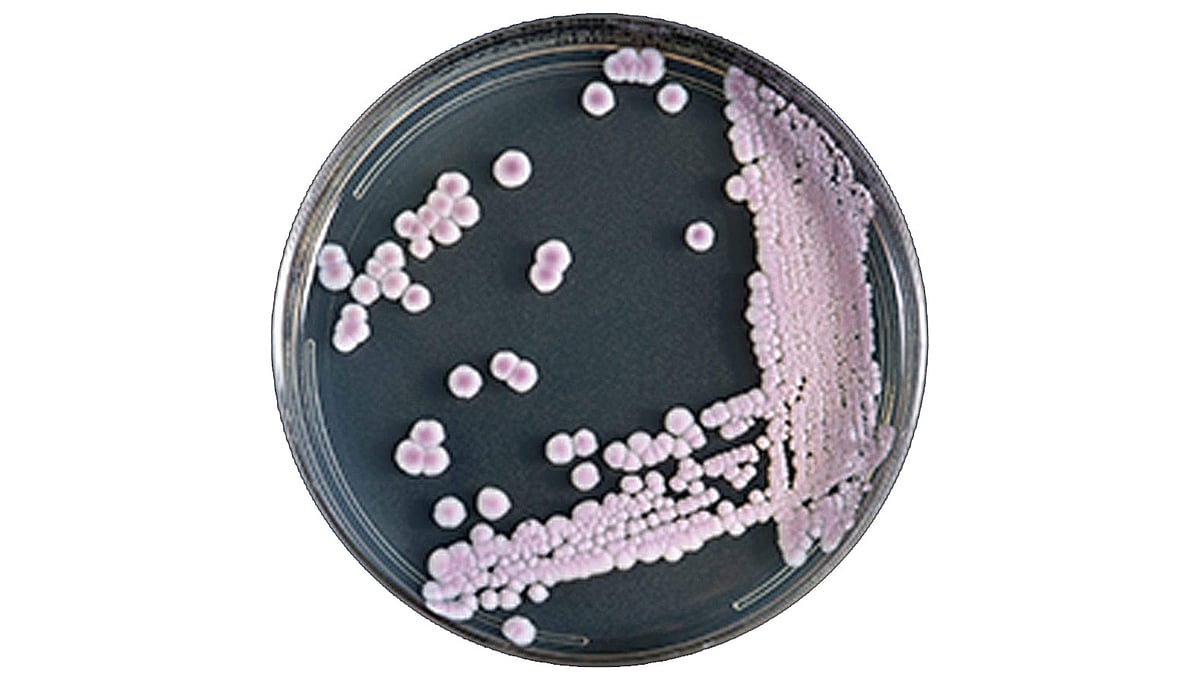

আমেরিকার সেন্টার ফর ডিসিজ কন্ট্রোল (সিডিসি) সম্প্রতি জানিয়েছে, নিউইয়র্ক অঙ্গরাজ্যে রোগ প্রতিরোধকারী অ্যান্টিবায়োটিকের মধ্যে ক্ষতিকারক এক ধরনের ছত্রাক রয়েছে। ক্যান্ডিডা আউরিস নামের এ ক্ষতিকারক ছত্রাকের উপস্থিতি বেশ আশঙ্কাজনক মাত্রায় পাওয়া গেছে।
সিডিসি এই ‘ক্যান্ডিডা আউরিস’কে বিশ্ব স্বাস্থ্যের জন্য গুরুতর হুমকি বলে অভিহিত করছে। হাসপাতালে দীর্ঘ সময় থাকতে হয় বা ক্যাথেটার ব্যবহার করেন বা অ্যান্টিবায়োটিক গ্রহণ করেন এমন ব্যক্তিদের এই ছত্রাক থেকে বেশি ক্ষতিগ্রস্ত হওয়ার আশঙ্কা রয়েছে।
ক্যান্ডিডা আউরিস নামের এ ছত্রাক সাধারণত মানুষের চামড়া ও শ্বসন ঝিল্লিগুলোতে বসবাস করে। নিউইয়র্ক টাইমসের তথ্যমতে, ইংল্যান্ড, স্পেন, ভারত, ভেনেজুয়েলা ও আমেরিকায় ওষুধের মধ্যে এ ছত্রাকের উপস্থিতি শনাক্ত হয়েছে। বেশ কয়েকটি দেশের স্বাস্থ্যসেবা কর্মকর্তারা জানিয়েছেন যে, হাসপাতালে রোগীদের মধ্যে ক্যান্ডিড আউরিস নামে পরিচিত এই ছত্রাকটি গুরুতর অসুস্থতা সৃষ্টি করেছে। বিশেষত কিছু রোগীর রক্তপ্রবাহের সঙ্গে মিশে গিয়ে এ ছত্রাক ভয়াবহ সংক্রমণ সৃষ্টি করছে। ছত্রাক-বিরোধী ওষুধ প্রয়োগেও এ সংক্রমণ থেকে নিরাময় পাওয়া কঠিন। অনেক সময় অ্যান্টিফাংগাস ওষুধে সাড়া না দিয়ে উল্টো সমস্যা তৈরি করে। শরীরের রোগ প্রতিরোধ ক্ষমতা কম, বিশেষত বয়স্ক ও শিশুরা এ ক্ষেত্রে বেশি ঝুঁকিতে রয়েছে।
সিডিসি বলছে, প্রচলিত পরীক্ষাগার পদ্ধতির মাধ্যমে এ ছত্রাক শনাক্ত করা কঠিন। ক্যান্ডিডা আউরিস ছত্রাকটি দ্বারা রক্ত প্রবাহ, ক্ষত ও কানে সংক্রমণ হতে পারে। এই ছত্রাকে শ্বাসযন্ত্র ও প্রস্রাবের পথেও ইনফেকশন তৈরি হতে পারে। এমনকি ফুসফুস ও মূত্রাশয়ে সংক্রমণের কারণও হতে পারে বলে ধারণা করা হচ্ছে। তবে এ বিষয়টি এখনো নিশ্চিত নয়।
এখন পর্যন্ত নিউইয়র্ক অঙ্গরাজ্যে ক্যান্ডিডা আউরিসে আক্রান্ত বেশ কিছু রোগী পাওয়া গেছে। এ অবস্থায় রোগীদের চিকিৎসা করতে গিয়ে ব্যবস্থাপত্রে নির্দেশিত অ্যান্টিবায়োটিকের মাধ্যমে ক্যান্ডিডা আউরিস ছত্রাক ছড়িয়ে পড়ছে কিনা সে বিষয়ে নিশ্চিত হওয়ার জন্য চিকিৎসকদের সতর্ক করে দিয়েছে সিডিসি।